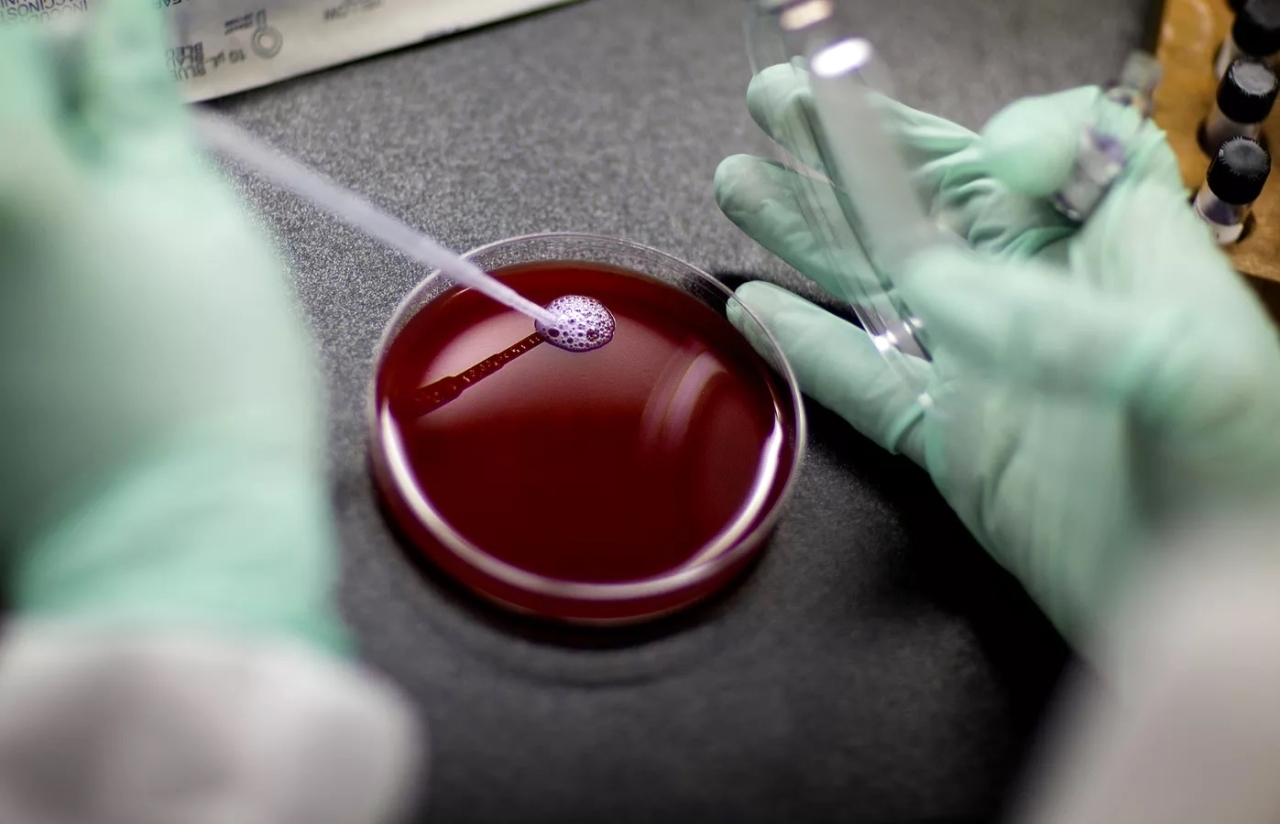

وافقت إدارة الغذاء والدواء الأمريكية، الجمعة، على أول دواء يستخدم أداة تحرير الجينات الثورية «كريسبر» لعلاج مرض فقر الدم المنجلي.
ووافقت الجهات التنظيمية في الإدارة على علاجين جينيين، أحدهما يستخدم تقنية «كريسبر» الحائزة على جائزة «نوبل»، وفقاً لبيان من إدارة الغذاء والدواء الأمريكية.